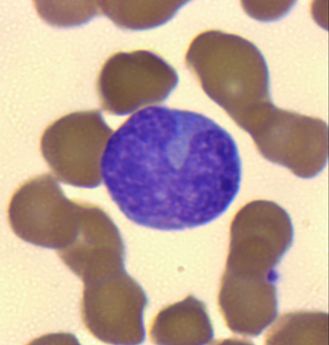

患者,男,90岁,有痔疮及便秘史10余年,7年前在某骨科医院行“左侧髋关节置换术”,因呕血4小时入院,血常规结果:WBC 1.67×109/L,RBC 2.94×1012/L,HGB 92g/L,MCV 100.3 fL,PLT 87×109/L。由于触犯较多复检规则,我们进行了推片、染色、镜检,发现白细胞确实少见、细胞巨幼样变、中性粒细胞分叶过多情况,如图1、2、3形态学镜检结果:白细胞减少明显,分类以中性粒细胞为主,偶见早幼粒细胞,未见原始粒细胞,多数粒细胞胞浆内可见中毒颗粒;可见少量有核红细胞,红细胞大小不均,大小红细胞及嗜多色性红细胞、巨红细胞可见;血小板散在可见,偶见大血小板。结论及建议:1、建议骨髓涂片检查,除外MDS;建议贫血三项检查,除外巨幼细胞性贫血。血常规结果中,需要注意的是红细胞平均体积 MCV为100.3 fL(参考范围86~100fL),在上限范围附近,但镜检发现却有巨幼样变红细胞?MCV不应该是更高一些吗?这是因为患者体内具有大、小红细胞,在血球仪分析时,综合所有红细胞体积后,就得出稍微高一点点的MCV。由于10.31号时,患者的白细胞下降到2.73×109/L,临床或有其它不解之处,便邀请我科一同探讨。会诊时介绍患者相关情况后,经管医生表示,27号患者的白细胞已达危急值水平,临床立即给予粒细胞刺激因子100ug,皮下注射。29号复查,白细胞上升至5.63×109/L。呼吸内科结合检查、症状,考虑急性喘息性支气管炎。普外科结合查体及检查,考虑肠梗阻,以小肠充气为主。此时,我科结合镜检涂片、生化结果中的同型半胱氨酸Hcy:30.16 umol/L↑(参考范围0~15 umol/L),提出怀疑是巨幼细胞性贫血,建议临床骨髓涂片和贫血三项检查。但临床反馈,患者年纪较大,家属拒绝,认为是有创检查。临床采纳贫血三项建议。会诊后,继续跟进患者情况,贫血三项结果如表2据此,我们怀疑患者是巨细胞性贫血中的单纯的叶酸缺乏性贫血,同时,我们外送了全血叶酸和红细胞叶酸检查,如图4,发现患者是红细胞叶酸浓度下降。这里需要注意区别两个叶酸的意思,叶酸在红细胞与血清的浓度相差几十倍。贫血三项中的叶酸是指血清叶酸,它是最近叶酸摄入量的指标;红细胞叶酸是长期叶酸贮存的最佳指征。低水平的RBC叶酸值可表明长期的叶酸缺乏[1]。
会诊时,我们根据血涂片及同型半胱氨酸,怀疑是巨幼细胞性贫血,是因为:叶酸和维生素B12是同型半胱氨酸代谢过程中的重要辅酶,维生素B12、叶酸分别为同型半胱氨酸变为蛋氨酸的代谢循环中一碳单位的传递体、蛋氨酸合成酶的辅酶。故叶酸或维生素B12缺乏导致Hcy分解代谢障碍,引起Hcy在体内堆积,导致患者Hcy水平增高。[2]
患者的血清叶酸下降,镜检见大红细胞、多分叶核中性粒细胞,已经有很大可能的指向巨细胞性贫血,但我们仍不能排除骨髓增生异常综合征,因为缺乏骨髓穿刺结果的佐证。最终临床诊断:骨髓增生异常综合征,骨髓可见巨幼样改变等病态造血现象,叶酸、Vit B12水平不低且补之无效。而巨细胞贫血中,骨髓呈典型的巨幼样改变,但无其他病态造血表现,叶酸实验性治疗补之有效。[3]
本案例中,虽然叶酸下降,但可能是患者年纪较大、长期摄入障碍或吸收障碍所致,所以并不能排除MDS存在。MA和MDS在本案例中,唯一可以鉴别就是骨髓穿刺是否可见病态造血现象。
其次,也可进行叶酸实验性治疗鉴别。但可惜的是后续血常规中血小板也出现危急值,但家属拒绝输注,认为输注血小板不能解决根本问题,患者不久便死亡。综合回顾性信息及检查、病历记录,个人比较倾向于MDS伴随诸多并发症导致的死亡。
【参考文献】
[1]检验视界网公众号文章《检验每天懂一点叶酸》,2016-11-21
[2]吴志成,陈娟,白丽霞.血清同型半胱氨酸水平与巨幼细胞性贫血相关研究[J].临床和实验医学杂志,2010,09(14):1067-1068
[3]葛均波,徐永健,王辰.内科学第九版[M].北京:人民卫生出版社,2018:544-546